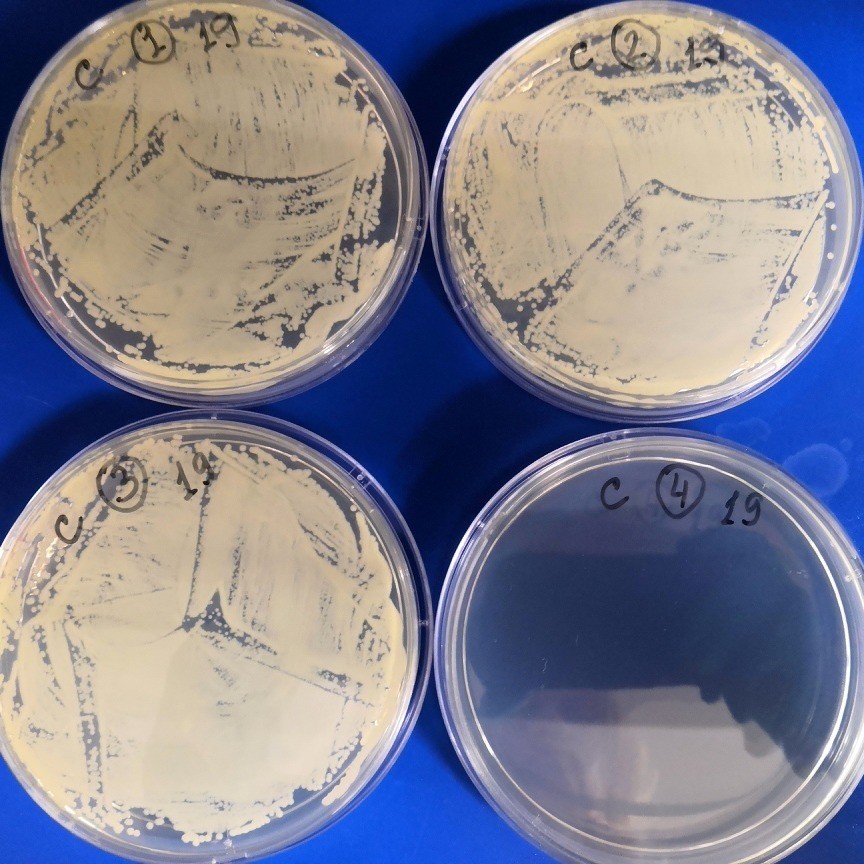

Российские учёные совместно с коллегами из Бразилии разработали бактерицидный материал, который можно применять в составе красок и покрытий в инфекционных и хирургических отделениях. В перспективе разработка может также использоваться при создании медицинских имплантов. В её основе — глинистый материал с добавлением наночастиц серебра и фосфорномолибденовой кислоты. Последняя усиливает высвобождение ионов серебра, которые убивают патогенные микроорганизмы.

- Gettyimages.ru
- © fatido
Учёные из Губкинского университета, Института физической химии и электрохимии имени А.Н. Фрумкина РАН, Медицинского университета Караганды и Химического института Сан-Карлоса (Бразилия) создали материал, который может стать альтернативой традиционным антибиотикам для уничтожения патогенных бактерий и бактериальных биоплёнок. Разработку можно использовать в составе красок или других материалов для обработки поверхности предметов, мебели и инструментов. В перспективе технология также может найти применение в медицине, в частности при создании имплантов. Об этом RT сообщили в пресс-службе РНФ. Исследование поддержано грантом фонда. Результаты опубликованы в журнале JCIS Open.
Как отметили авторы работы, антибактериальные покрытия применяются в медицинских учреждениях, пищевых производствах, а также в быту. Одним из часто используемых антибактериальных компонентов является коллоидное серебро — раствор наночастиц металла. Наночастицы способны бороться не только с бактериями, но и с их биоплёнками (колониями микроорганизмов, клетки которых прикреплены друг к другу. — RT). Такие биоплёнки особенно устойчивы к антибиотикам и антисептикам.
- Соединение с наночастицами серебра уничтожает биоплёнку
- © Дмитрий Копицын
Учёные разработали материал с антибактериальным и антибиоплёночным эффектом. Он представляет собой композит из наночастиц серебра и фосфорномолибденовой кислоты на носителе из природного минерала галлуазита.
Исследователи нанесли серебро на глинистый носитель, что обеспечило материал антибактериальными свойствами. Фосфорномолибденовая кислота играет в композите роль окислителя и была добавлена для увеличения активности высвобождения ионов серебра.
Авторы работы подтвердили эффективность нового материала в лабораторных условиях. Они нанесли вещество на биоплёнки бактерий Staphylococcus aureus, Pseudomonas aeruginosa и Acinetobacter baumannii, вызывающих пневмонию и болезни мочевыводящих путей. Эксперименты показали, что композит подавляет рост микроорганизмов в два раза эффективнее, чем обычный раствор из наночастиц серебра. Более того, материал снизил жизнеспособность биоплёнок патогенных бактерий более чем на четыре порядка.
По словам разработчиков, полученный материал нужно применять в более высокой концентрации, чем традиционные антибиотики. Однако он хорошо подходит для локального применения в составе красок или других материалов для обработки поверхности предметов, мебели, инструментов. Это позволит предотвратить распространение бактерий, устойчивых к противомикробным препаратам, что особенно актуально в условиях инфекционных и хирургических стационаров.

- Gettyimages.ru
- © Morsa Images
Если заменить фосфорномолибденовую кислоту на более биосовместимые компоненты, то в будущем такие вещества можно применять и в медицине, отметили исследователи.
«Проведение хирургических операций часто осложняют хронические болезни пациента или процессы нагноения, возникающие из-за бактериальных заражений. Приходится добавлять локально много антибиотиков, что может вызвать устойчивость бактерий к ним. Сейчас мы работаем над тем, чтобы наш материал можно было включать в состав костных цементов или покрывать им поверхность имплантов, чтобы повысить их приживаемость и избежать нагноения после операции», — рассказал RT руководитель проекта, ведущий научный сотрудник Губкинского университета Дмитрий Копицын.
